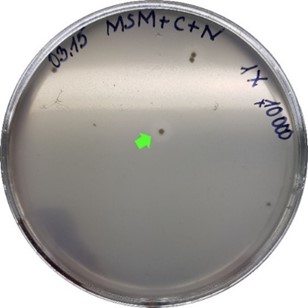

INGA MATIJOŠYTĖ
Senior Researcher
Head, Division of Applied Biocatalysis
Institute of Biotechnology
Email:
Phone: +370 5 223 4371
RESEARCH OVERVIEW
Biocatalysis, which applies natural biological substances (microorganisms, enzymes etc.) in various industrial processes, is one of the most popular alternatives to traditional technologies. The use of such biocatalysts fulfils the requirements that are needed for sustainable synthesis. They are very appealing as they exhibit high enantio- and region-selectivity toward targeted substrates and function under mild reaction conditions: a water/buffer medium, ambient reaction temperatures, no pressure is required. These advantages allow avoiding the burden of group-protecting procedures, saving time, materials (including the harsh, dangerous or toxic ones) and energy costs. Other advantages of biocatalysts are that they are easy to control and biodegradable. Thus, biocatalysis has proved, in many cases, to be a more superior pathway than the pathways of conventional chemical synthesis, not only in the simplicity of accomplishing the reactions but also from an economical and environmental point of view. Currently, enzymes are already used in many industries such as food, detergents, textiles, leather, wood and paper manufacturing, diagnostics and therapy, pharmaceuticals etc. Due to their wide application, the market of enzymes is growing very fast every year. Today, more than 180 biocatalytic processes are implemented in industrial settings.
Our team focuses on the discovery and engineering of biocatalysts with properties for potential industrial application and development of efficient biocatalytic routs for producing the high-added value products from bio-based raw materials or industrial by-products. The sector’s research is based on developing biocatalytic systems by screening for enzymes (environmental samples, enzyme and strain collections, metagenomic and expression libraries, the development of screening systems etc.); the development of biocatalysts (gene engineering, the development of analytical systems, protein purification, the development of expression systems etc.); the application of biocatalysts (immobilization, recycling, proof of principal activity/selectivity, stability, reaction media, an improved efficiency of bioconversions, the quality analysis of products obtained by biocatalysis etc.). We also strive to meet scientific challenges in the application of Green Chemistry principles in technologies and processes.
SELECTED PUBLICATIONS
- Baliukynas, M., Veteikytė, A., Kairys, V., Matijošytė, I. The hydrolysis of indoxyl acetate: a versatile reaction to assay carbonic anhydrase activity by high-throughput screening. Enzyme Microb. Technol. 2020, 136: 109584.
- Rotter, A., Bacu, A., Barbier, M., Bertoni, F., Bones, A. M., Cancela, M. L., Carlsson, J., Carvalho, M. F., Cegłowska, M., Dalay, M. C., Dailianis, T., Deniz, I., Drakulovic, D., Dubnika, A., Einarsson, H., Erdoğan, A., Eroldoğan, O. T., Ezra, D., Fazi, S., FitzGerald, R. J., Gargan, L. M., Gaudêncio, S. P., Ivošević DeNardis, N., Joksimovic, D., Kataržytė, M., Kotta, J., Mandalakis, M., Matijošytė, I., Mazur-Marzec, H., Massa-Gallucci, A., Mehiri, M., Nielsen, S. L., Novoveská, L., Overlingė, D., Portman, M. E., Pyrc, K., Rebours, C., Reinsch, T., Reyes, F., Rinkevich, B., Robbens, J., Rudovica, V., Sabotič, J., Safarik, I., Talve, S., Tasdemir, D., Schneider, X. T., Thomas, O. P., Toruńska-Sitarz, A., Varese, G. C. and Vasquez, M. I. A new network for the advancement of marine biotechnology in Europe and bBeyond. Front. Mar. Sci. 2020, 7: 278. doi: 10.3389/fmars.2020.00278.
- Šulcienė, M., Kolvenbach, B., Ammann, E., Matijošytė, I. Towards an affordable enzymatic production of biopolyols –comparing the immobilization of lipases by two optimized techniques. Int. J. Biol. Macromol. 2018, 116: 1049–1055.
- Malūnavičius, V., Druteika, G., Sadauskas, M., Veteikytė, A., Matijošytė, I., Lastauskiene, E., Gegeckas, A., Gudiukaite, R. Usage of GD-95 and GD-66 lipases as fusion partners leading to improved chemiric enzyme LipGD95-GD66. Int. J. Biol. Macromol. 2018, 15 (118): 1594–1603.
RESEARCH ACTIVITIES in 2020
Synthetic Polymer Biodegradation
One of the sector’s topics of interest is biodegradation of various synthetic polymers. It is a relatively new field of research focusing on finding possible ways to degrade synthetic polymers that comprise a major industrial and environmental problem – plastic containing waste. Such waste has a significant ecological impact and is being increasingly regulated on the European Union level. For example, the EU proposed a ban of burying recyclable waste in landfills, and a goal of ensuring that all plastic packaging is reusable or recyclable by 2030. Synthetic polymers are used in various sectors, hence their recyclability is different and depends on their chemical structure. One of the hardiest synthetic polymers are polyurethanes (PU). Nonetheless, it is known to be biodegradable to some extent. The goals of our research are to explain this biodegradation phenomenon and to identify enzymes and organisms that are capable to degrade it. For this purpose, various environmental samples have been screened to identify PU degrading organisms. In total, bacteria belonging to eleven different genera have been isolated as potential PU degraders. One of the isolated bacteria, Lysinibacillus sp., contained a gene coding an enzyme that has urethanase activity (ID: TBS 101 urethanase). This enzyme could potentially be used to hydrolyse urethane bond in polyurethane.

Fig. 1. Molecular docking of urethanase using urethane as a substrate.
Fig. 2. Hydrolysis zone formed by Rhodococcus sp. on a selective growth media containing polyether polyurethane. Bacteria was isolated from Lithuanian soil.
Synthesis of Substrates for Functional Analysis
Laccase is an oxidoreductase used for various applications such as bioremediation, biofuel production, textile pre-treatment, paper pulp manufacturing, food processing, improvement of household chemicals, organic synthesis and many more. However, this enzyme shows potential for even higher applicability and could substitute the most common commercial oxidizing agent – hydrogen peroxide. Nonetheless, current laccase research and utilization are limited by a few factors. One of these factors is a lack of substrate variety for the enzyme functional analysis. Therefore, in the current PhD project, we are creating and investigating specifically designed polyamine compounds for laccase spectrophotometric activity assay, well-plate and agar-plate based screening methods. Recent results have shown that one of the agar-plate methods can selectively detect laccase activity as low as 0.1 U/ml (1 U/ml = 1 μmol metol catalysed in a minute at pH 5.0 and room temperature by Novozym® 51003 laccase).The collection of wild fungi protein extracts provided by Jožef Stefan Institute, Slovenia, was screened using this method

Fig. 3. Visual presentation of the developed agar-plate screening method
European Transdisciplinary Networking Platform for Marine Biotechnology
Marine organisms produce a vast diversity of various enzymes, proteins, metabolites etc. Marine biomass itself can serve as the source material for the production of various bulk commodities (e.g. biofuels, bioplastics, biomaterials). The sustainable exploitation of marine bio-resources and the development of biomolecules and polymers are also known as the growing field of marine biotechnology. Up to now, over 35 000 natural products have been identified from marine organisms, but many more are yet to be uncovered, as the vast diversity of biota in the marine systems remains largely unexplored. Since marine biotechnology is still in its infancy, there is a need to create effective, operational, inclusive, sustainable, transnational and transdisciplinary networks with a serious and ambitious commitment for knowledge transfer, training provision, dissemination of best practices and identification of the emerging technological trends through science communication activities. The Sector of Applied Biocatalysis took part in the establishment of such collaborative framework - Ocean4Biotech (www.ocean4biotech.eu), an Action within the European Cooperation in Science and Technology (COST), which connects stakeholders with an interest in marine biotechnology in Europe and beyond. The scientific collaboration agreement with the University of Torino was signed in 2020, another agreement with Jožef Stefan Institute, Slovenia, will be launched in 2021. Close collaboration with Marine Research Institute of Klaipėda University, Lithuania, resulted in a joint publication and a thesis for scientific conferences.

Novel High-Performance Polymers from Lignocellulosic Feedstock
It is becoming increasingly clear that the society at large and the whole industry in particular need a transition from an unsustainable, fossil based linear economy to a sustainable circular economy, based on the utilization of solar energy. Bio-based chemicals have great potential to reduce and replace the fossil feedstock used by chemical industry today. The project develops a new sustainable platform for novel bio-derived polymers used in applications with strict demands for properties (e.g. automotive industry, coatings, packaging etc). As a raw material, a stream of wood sugars, which very recently became available and are derived from low quality wood residues, is used. Importantly, the environmental benefits and possible adverse effects are fully analysed throughout the project, enabling the optimization from the sustainability point of view. The environmental sustainability profile of the bio-based polymers studied will be benchmarked against the conventional fossil-derived plastics. The project under Baltic Research Programme is implemented by close collaboration of the Sector of Applied Biocatalysis, University of Tartu, Norwegian University of Science and Technology and the Estonian company Graanul Invest.